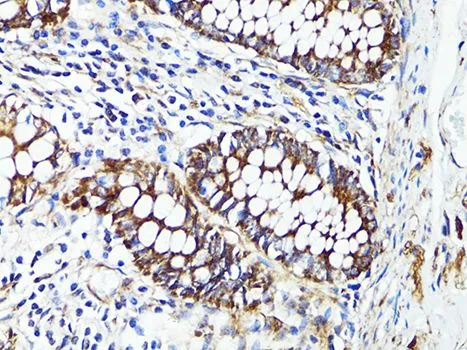

IHC-P analysis of human colon tissue using GTX65938 S100A10 antibody. Dilution : 1:100
S100A10 antibody
GTX65938
ApplicationsWestern Blot, ImmunoHistoChemistry, ImmunoHistoChemistry Paraffin
Product group Antibodies
ReactivityHuman, Monkey, Mouse
TargetS100A10
Overview
- SupplierGeneTex
- Product NameS100A10 antibody
- Delivery Days Customer9
- Application Supplier NoteWB: 1:500 - 1:2000. IHC-P: 1:50 - 1:200. *Optimal dilutions/concentrations should be determined by the researcher.Not tested in other applications.
- ApplicationsWestern Blot, ImmunoHistoChemistry, ImmunoHistoChemistry Paraffin
- CertificationResearch Use Only
- ClonalityPolyclonal
- ConjugateUnconjugated
- Gene ID6281
- Target nameS100A10
- Target descriptionS100 calcium binding protein A10
- Target synonyms42C, ANX2L, ANX2LG, CAL1L, CLP11, Ca[1], GP11, P11, p10, protein S100-A10, S100 calcium binding protein A10 (annexin II ligand, calpactin I, light polypeptide (p11)), annexin II ligand, calpactin I, light polypeptide, annexin II tetramer (AIIt) p11 subunit, calpactin I light chain, calpactin-1 light chain, cellular ligand of annexin II
- HostRabbit
- IsotypeIgG
- Protein IDP60903
- Protein NameProtein S100-A10
- Scientific DescriptionThe protein encoded by this gene is a member of the S100 family of proteins containing 2 EF-hand calcium-binding motifs. S100 proteins are localized in the cytoplasm and/or nucleus of a wide range of cells, and involved in the regulation of a number of cellular processes such as cell cycle progression and differentiation. S100 genes include at least 13 members which are located as a cluster on chromosome 1q21. This protein may function in exocytosis and endocytosis. [provided by RefSeq, Jul 2008]
- ReactivityHuman, Monkey, Mouse
- Storage Instruction-20°C or -80°C,2°C to 8°C
- UNSPSC41116161







![ICC/IF analysis of HeLa (left) and L-02 (right) cells using GTX83075 S100A10 antibody [4E7E10]. Green : S100A10 Blue: DRAQ5 fluorescent DNA dye Red: Actin filaments](https://www.genetex.com/upload/website/prouct_img/normal/GTX83075/GTX83075_20170912_ICCIF_w_23061322_662.webp)
